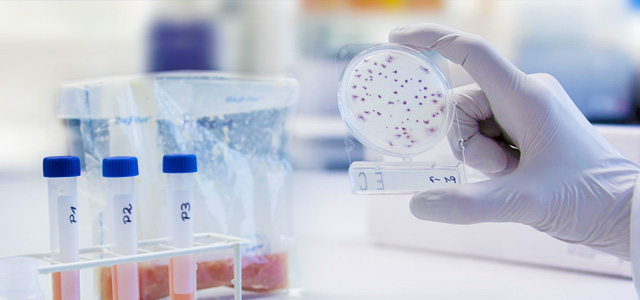

Are you a medical aspirant? Whether you are seeking medical education or wish to make a successful career in the medical industry, know all about the trending microbiology career for yourself.
When it comes to pursuing a lucrative career in the field of biology, microbiology is a field or sub-branch that has been gaining huge popularity in the modern time. The field of Microbiology is known to encompass various other biology fields including Virology, Mycology, Bacteriology, and Parasitology. The professionals in the given field are referred to as Medical Microbiologists. They are mostly concerned about identifying the causes of various types of diseases and coming across ways to combat the same. Thus, the role of a Medical Microbiologist comes with various responsibilities. The professionals in the given industry are also responsible for tracking down as well as identifying new pathogens that lead to a host of other diseases.
Choosing the Top colleges will help You to get highest paying job. You must find a list of top 10 microbiology colleges in India before making taking admission in this field.
Eligibility Criteria for Microbiology
When you wish to apply for the role of a Medical Microbiologist, you are required to fulfill the eligibility criteria as:
- 10+2 with subjects including Physics, Zoology, Botany, and Chemistry with at least 50 percent marks combined for pursuing B.Sc. in Microbiology
- The degree holders of B.Sc. in Microbiology can look forward to pursuing M.Sc. in Microbiology in various fields including:
- Biochemistry
- Medical Microbiology
- Bioinformatics
- Industrial Microbiology
- Food Microbiology
- Forensic Science
- Clinical Research
- Hospital Management
Career Prospects
As far as the career prospects of Microbiology are concerned, there are ample opportunities in the given field. Once you complete the Post-Doctoral studies or Ph.D. in Microbiology, you can go for getting through TOEFL or GRE to get your scholarships and then apply for lucrative microbiology jobs at some of the leading foreign universities or Research & Development institutions. You can also look forward to becoming a teaching professional in the field of Microbiology as you get the opportunity to guide teams and aspirants in the given field in leading colleges and institutions of the world.
Salary
As a professional microbiologist, you get the opportunity to work with leading research & development teams in the field of microbiology. As such, you can expect a lucrative salary along with several perks.
Additional read: Top 10 medical colleges in world